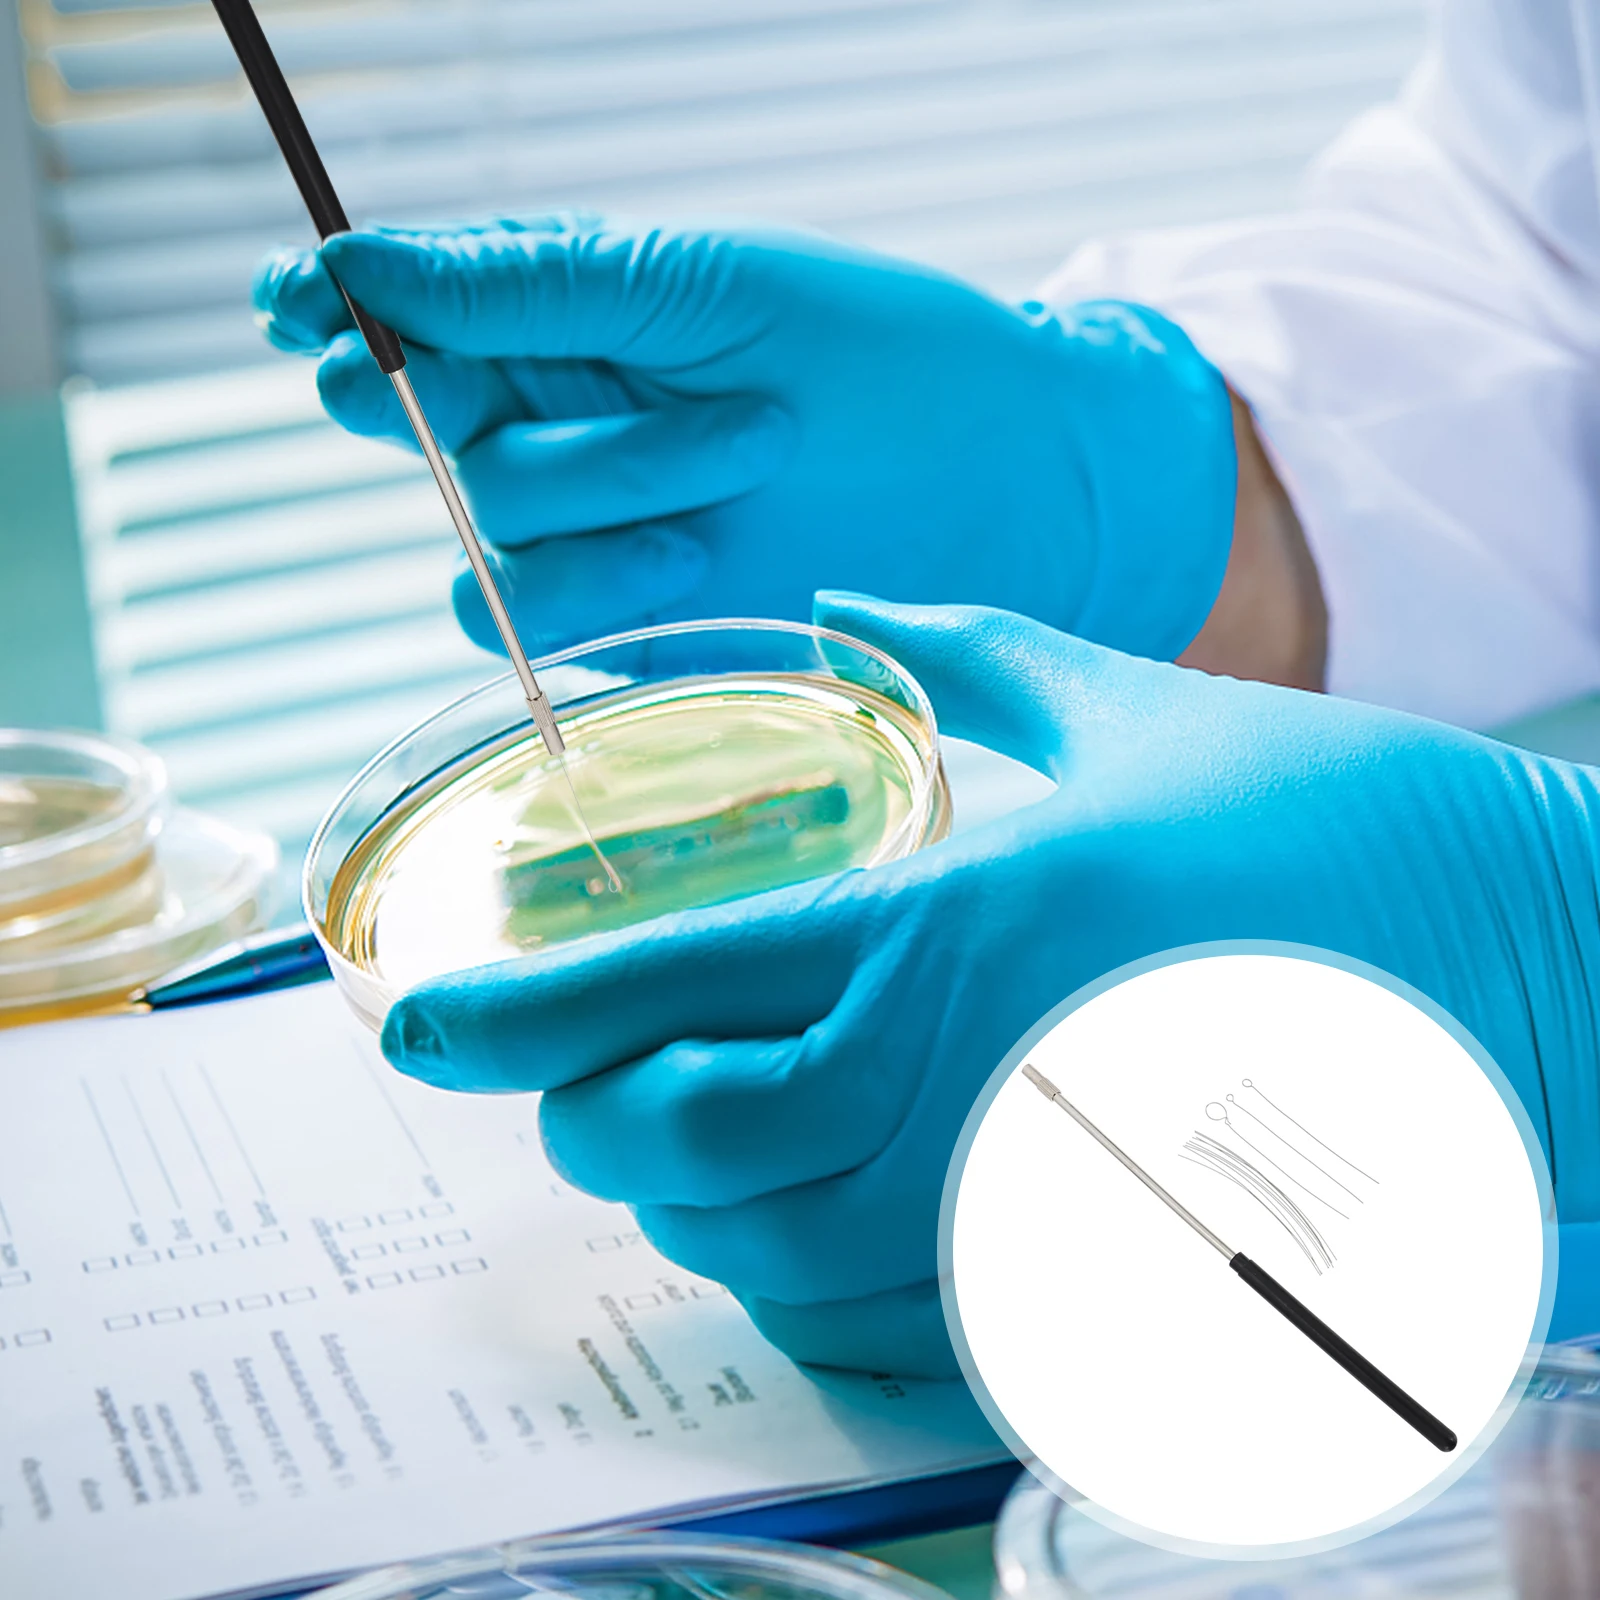
thumb

Copper Inoculating Laboratory Parts Set Microbiology Lab Tools Loops Replacement Rings Laboratory Supplies Device
Price history chart & currency exchange rate
Customers also viewed

$9.59
George Clooney Scaled Art Throw Pillow Cushion Cover For Sofa christmas pillow case Pillow
aliexpress.com
$65.04
Ultrasounds Therapy Machine for Pain Relief Ultrasonics Physiotherapys 1MHz Smart Muscle Massager Drug Free Adults Body Massages
aliexpress.com
$77.11
Wind wheel impeller wheel centrifugal centrifugal fan impeller fan blower stainless steel
aliexpress.com
$14.00
Industrial Robotic Arms X-Ray Hologram. Industrial and Technology Concept. Interface element 4k 60 fps animation
creativemarket.com
$14.19
Men polo shirt long-sleeve lapel 2019 new autumn black thin smart casual trend student male polo shirt teenage boy P07b
aliexpress.com
$3.59
Чехол Awog на Samsung Galaxy A52s / Самсунг A52s "Розовая цветочная рамка", Разноцветный, 2106550-8
goods.ru
$1.69
Кольцо гильзы цилиндра (прокладка) Газель, Волга двигатель 402, ГАЗ 53 медное (компл.4шт) (производ. Россия)
bigl.ua
$13.93
Metal Wire Fruit Bowl Basket Storage Holder Stand Kitchen Vegetable Rack Storage Stand Produce Serving Tray Organizer
aliexpress.com
$84.00
Smart Watch Men AMOLED 454*454 1.39inch HD Screen BT Call Music Playback Sport Heart Rate Monitor Smartwatch IOS Android VS KK70
aliexpress.com
$20.00
Professional Football Game Tactics Board Leather Magnetic Foldable Portable Standing Layout Special for Postgame Replay Teaching
aliexpress.com
$14.75
Чехол для подушки с рисунком в стиле аниме дакимакура черного цвета, наволочка для обнимающей подушки, высококачественный декоративный чех...
aliexpress.com
$21.88
YIZZHOY Spring Autumn Lady Elegant Beading Solid Color White Dress Women Vintage Mandarin Collar Lantern Sleeve Slim Dress
aliexpress.com
$3.14
Vintage Women's Corduroy Handbag Shoulder Messenger Bag Satchel Tote Purse Crossbody Bags
aliexpress.com
$56.51
Муж. Мокасины Замша Лето / Осень На каждый день / Английский Башмаки и босоножки Дышащий Контрастных цветов Черный / Серый / Хаки
lightinthebox.com